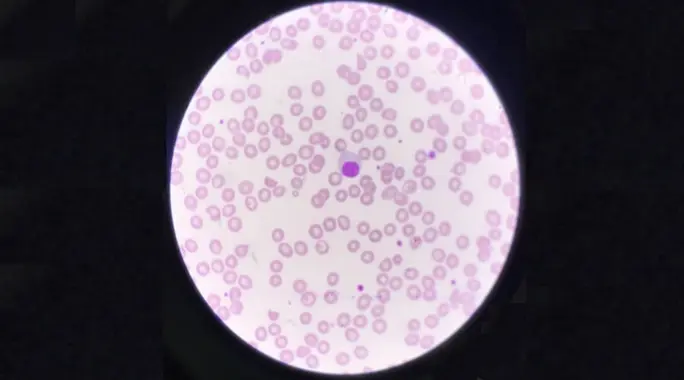

الخلايا الليمفاوية هي جنود جهازك المناعي، تحارب الغزاة وتدافع عن صحتك. ولكن ماذا يحدث عندما ينخفض عدد هذه الخلايا الحيوية؟ تُعرف هذه الحالة بانخفاض الخلايا الليمفاوية، أو قلة اللمفاويات، ويمكن أن تؤثر بشكل كبير على قدرة جسمك على مقاومة الأمراض.
في هذا المقال، سنستكشف بعمق ماهية انخفاض الخلايا الليمفاوية، ونستعرض الأسباب المتعددة التي قد تؤدي إليه، بالإضافة إلى الأعراض التي يجب الانتباه لها، وطرق التشخيص والعلاج المتاحة. دليلك الشامل لفهم هذه الحالة وإدارة صحتك المناعية بفعالية.
جدول المحتويات:
- ما هو انخفاض الخلايا الليمفاوية (Lymphopenia)؟
- أعراض انخفاض الخلايا الليمفاوية: علامات لا يجب تجاهلها
- أسباب انخفاض الخلايا الليمفاوية: فهم المسببات المختلفة
- عوامل الخطر المرتبطة بانخفاض الخلايا الليمفاوية
- تشخيص انخفاض الخلايا الليمفاوية: الطريق إلى الفهم
- علاج انخفاض الخلايا الليمفاوية: نهج مخصص لكل حالة
- نصائح لتعزيز المناعة والوقاية من انخفاض الخلايا الليمفاوية
ما هو انخفاض الخلايا الليمفاوية (Lymphopenia)؟
الخلايا الليمفاوية هي نوع حيوي من كريات الدم البيضاء، التي تشكل جزءًا أساسيًا من جهازك المناعي. تساعد هذه الخلايا الجسم على محاربة العدوى والأمراض، وتلعب دورًا محوريًا في الاستجابة المناعية.
يحدث انخفاض الخلايا الليمفاوية، أو قلة اللمفاويات، عندما لا يحتوي مجرى الدم على عدد كافٍ من هذه الخلايا. عادةً ما يُعتبر انخفاضًا إذا كان عدد الخلايا الليمفاوية أقل من 1000 خلية لكل مايكروليتر من الدم لدى البالغين. أما بالنسبة للأطفال، فإن هذا الرقم ينخفض إلى أقل من 3000 خلية لكل مايكروليتر.
من المهم ملاحظة أن المستويات الطبيعية قد تختلف قليلًا بناءً على نوع الاختبار والمختبر الذي يجريه، ولذلك، يُعد التفسير الطبي ضروريًا دائمًا.
أعراض انخفاض الخلايا الليمفاوية: علامات لا يجب تجاهلها
في بعض الحالات الخفيفة، قد لا تظهر أي أعراض واضحة تدل على انخفاض الخلايا الليمفاوية. ومع ذلك، في حالات أخرى، يمكن أن تظهر مجموعة من العلامات التي تشير إلى وجود مشكلة في الجهاز المناعي.
من أبرز هذه الأعراض التي تستدعي الانتباه، والتي قد تكون مؤشرًا على وجود حالة كامنة تتسبب في قلة اللمفاويات، نذكر ما يلي:
- الحمى المستمرة أو المتكررة.
- السعال المزمن أو الذي لا يزول.
- سيلان الأنف المستمر دون سبب واضح.
- تضخم الغدد الليمفاوية في الرقبة، الإبطين، أو الفخذ.
- صغر حجم العقد الليمفاوية أو اللوزتين بشكل غير طبيعي.
- ألم المفاصل الذي لا يرتبط بإصابة معينة.
- الطفح الجلدي غير المبرر.
- التعرق الليلي الغزير.
- فقدان الوزن غير المقصود والمفاجئ.
أسباب انخفاض الخلايا الليمفاوية: فهم المسببات المختلفة
تتنوع أسباب انخفاض الخلايا الليمفاوية بشكل كبير، ويمكن أن تتراوح من حالات طبية بسيطة إلى أمراض مزمنة أو وراثية. من الضروري فهم هذه الأسباب لتحديد العلاج المناسب.
الحالات الطبية والأمراض الكامنة
تؤدي بعض الأمراض إلى نقص في أنواع محددة من الخلايا الليمفاوية، مثل الخلايا التائية (T-cell) أو البائية (B-cell)، وتشمل هذه الأمراض:
- أمراض الدم، مثل مرض هودجكن.
- اضطرابات المناعة الذاتية، مثل الذئبة والتهاب المفاصل الروماتويدي، حيث يهاجم الجهاز المناعي أنسجة الجسم عن طريق الخطأ.
- الأمراض المعدية الشديدة، مثل السل، والإيدز، والتهاب الكبد الفيروسي.
- أنواع معينة من السرطانات، بما في ذلك سرطان الدم، وسرطان الجهاز اللمفاوي، وسرطان الغدد الليمفاوية.
- أمراض التهاب الأمعاء، مثل مرض كرون والتهاب القولون التقرحي، التي تؤثر على امتصاص العناصر الغذائية.
- الاضطرابات الهضمية الأخرى التي تمنع امتصاص الفيتامينات والمعادن.
- تعفن الدم (Sepsis)، وهو استجابة التهابية خطيرة للعدوى.
- نقص الزنك، وهو معدن حيوي لوظيفة المناعة.
العلاجات الطبية وبعض الأدوية
يمكن لبعض العلاجات الطبية أن تسبب انخفاضًا مؤقتًا أو دائمًا في عدد الخلايا الليمفاوية، ومنها:
- العلاج الإشعاعي، الذي يستهدف الخلايا سريعة الانقسام.
- العلاج الكيميائي، المستخدم في علاج السرطان، والذي يؤثر على خلايا الدم.
- العلاج بالستيرويد طويل الأمد.
العوامل الوراثية
بعض الحالات الوراثية النادرة يمكن أن تسبب نقصًا في الخلايا الليمفاوية منذ الولادة، ومنها:
- رنح توسع الشعيرات (Ataxia telangiectasia).
- متلازمة دي جورج (DiGeorge anomaly).
- متلازمة ويسكوت ألدريش (Wiskott-Aldrich syndrome).
- متلازمة نقص المناعة الشديد (Severe Combined Immunodeficiency).
أسباب غذائية ونقص التغذية
يؤثر سوء التغذية ونقص العناصر الغذائية بشكل مباشر على إنتاج الخلايا الليمفاوية ووظيفتها. يمكن أن يحدث هذا بسبب:
- نقص البروتين والمواد المغذية الأساسية اللازمة لإنتاج الخلايا الليمفاوية.
- اضطرابات الأكل، مثل فقدان الشهية العصبي، التي تسبب نقصًا حادًا في العناصر الغذائية.
عوامل الخطر المرتبطة بانخفاض الخلايا الليمفاوية
هناك عدة عوامل قد تزيد من احتمالية تعرضك لانخفاض الخلايا الليمفاوية. فهم هذه العوامل يساعد في اتخاذ تدابير وقائية أو طلب الرعاية الطبية في الوقت المناسب.
تشمل عوامل الخطر هذه ما يلي:
- الإصابة بعدوى حديثة، حيث قد يستنفد الجسم الخلايا الليمفاوية لمكافحة الميكروب.
- الخضوع لعملية جراحية مؤخرًا، والتي قد تسبب إجهادًا للجهاز المناعي.
- المعاناة من حالة مزمنة معروفة بأنها تسبب انخفاضًا في عدد الخلايا الليمفاوية.
- تناول بعض الأدوية التي تؤثر على إنتاج أو بقاء الخلايا الليمفاوية في الجسم.
تشخيص انخفاض الخلايا الليمفاوية: الطريق إلى الفهم
لتشخيص انخفاض الخلايا الليمفاوية وتحديد سببه الكامن، سيعتمد الطبيب على مجموعة من الفحوصات والتقييمات. يبدأ التشخيص عادةً بفهم شامل لتاريخك الصحي.
تتضمن الإجراءات التشخيصية الرئيسية ما يلي:
- الفحص البدني: يتضمن مراجعة تاريخك الطبي والبحث عن علامات مثل تورم الطحال أو الغدد الليمفاوية، والتي قد تشير إلى مشكلة مناعية.
- فحوصات الدم: يُعد ملف تعريف الخلايا الليمفاوية جزءًا أساسيًا لتحديد عدد وأنواع الخلايا الليمفاوية في الدم، مما يساعد في الكشف عن العدوى أو الاضطرابات الأخرى.
- اختبارات العقدة الليمفاوية: تُجرى هذه الاختبارات لتشخيص بعض الاضطرابات، بما في ذلك اضطرابات نقص المناعة الوراثي.
- قياس التدفق الخلوي (Flow Cytometry): يتيح هذا الاختبار قياس أنواع الخلايا الليمفاوية بتفصيل دقيق، بما في ذلك الخلايا التائية والبائية والخلايا القاتلة الطبيعية، مما يوفر معلومات قيمة عن وظيفتها.
- تحليل نخاع العظم: في بعض الحالات، قد يكون تحليل نخاع العظم ضروريًا للتحقق من إنتاج خلايا الدم واكتشاف أي شذوذ.
علاج انخفاض الخلايا الليمفاوية: نهج مخصص لكل حالة
يعتمد علاج انخفاض الخلايا الليمفاوية بشكل كبير على السبب الكامن وراء هذه الحالة. بمجرد تحديد السبب، يمكن للأطباء وضع خطة علاجية مخصصة تهدف إلى معالجة المشكلة الأصلية ورفع مستويات الخلايا الليمفاوية.
من أبرز العلاجات المستخدمة:
- العلاج المركب المضاد للفيروسات: يُستخدم إذا كان السبب عدوى فيروسية.
- أدوية المضادات الحيوية: تُوصف لعلاج العدوى البكتيرية التي قد تكون مسؤولة عن الانخفاض.
- الأدوية المضادة للفطريات: لمعالجة أنواع معينة من العدوى الفطرية.
- العلاج بالأجسام المضادة غاما غلوبين (Gamma globulin): يُعطى لمنع الالتهابات التي قد تسبب انخفاض الخلايا الليمفاوية البائية، ويعزز المناعة.
- زرع الخلايا الجذعية لنخاع العظم: في الحالات الشديدة أو الوراثية، قد يكون هذا الخيار ضروريًا لاستعادة وظيفة الجهاز المناعي.
نصائح لتعزيز المناعة والوقاية من انخفاض الخلايا الليمفاوية
على الرغم من أنه قد لا يكون من الممكن منع انخفاض الخلايا الليمفاوية بشكل كامل في جميع الحالات، إلا أن هناك خطوات قوية يمكنك اتخاذها لتعزيز جهازك المناعي وحماية جسمك من العدوى والأمراض التي قد تؤدي إلى هذه الحالة.
اتبع هذه النصائح لدعم صحتك المناعية العامة:
- تغذية صحية ومتوازنة: حافظ على نظام غذائي غني بالعناصر الغذائية الأساسية، مليء بالبروتين عالي الجودة، والفيتامينات والمعادن. هذه المغذيات ضرورية لإنتاج الخلايا المناعية ووظيفتها.
- تجنب الأطعمة غير المطبوخة جيدًا: تأكد دائمًا من طهي الطعام جيدًا، خاصة اللحوم والدواجن، لتجنب البكتيريا الضارة التي قد تسبب العدوى.
- الحصول على قسط كافٍ من النوم والراحة: النوم الجيد يعزز بشكل كبير من وظيفة جهازك المناعي وقدرته على مكافحة الأمراض.
- نظافة اليدين الفعالة: اغسل يديك جيدًا بالماء الدافئ والصابون لعدة مرات في اليوم، خاصة بعد استخدام الحمام، وقبل تحضير الطعام أو تناوله. استخدم معقمات اليدين التي تحتوي على الكحول عند عدم توفر الماء والصابون.
تُعد الخلايا الليمفاوية مكونًا حيويًا لجهاز المناعة، وفهم حالة انخفاض الخلايا الليمفاوية أمر بالغ الأهمية للحفاظ على صحة قوية. من خلال التعرف على الأسباب والأعراض، يمكنك اتخاذ خطوات استباقية نحو التشخيص والعلاج.
إذا كنت تشك في أنك تعاني من أعراض مرتبطة بانخفاض الخلايا الليمفاوية، فمن الضروري استشارة أخصائي الرعاية الصحية. يمكن للتشخيص المبكر والرعاية المناسبة أن تحدث فرقًا كبيرًا في إدارة هذه الحالة وتعزيز قدرة جسمك على محاربة الأمراض.